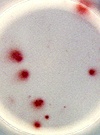

Другие названия и синонимы
Enzyme immunoassay (ELISA), Анализ на антитела к возбудителям инфекций.
Описание
Анализ связанного с ферментами иммуносорбента (ИФА) основан на обнаружении в крови специфических антител (иммуноглобулинов классов А, М и G) к антигенам возбудителей различных инфекционных заболеваний. Наличие антител может указывать как на текущую, так и на предыдущую инфекцию, поэтому определение титра AT и его изменение в динамике также имеют большое диагностическое значение. Увеличение титра специфических иммуноглобулинов в сыворотке крови в течение 10-14 дней, по крайней мере, в 4 раза указывает на активное течение инфекции. Метод ELISA широко используется для диагностики различных инфекционных заболеваний (включая урогенитальные инфекции), опухолевых маркеров, аутоантител к эндокринопатии, бесплодию и системным заболеваниям.
|
|
Номенклатурные коды
- A09.05.118 Исследование уровня антител к антигенам растительного, животного и химического происхождения в крови
- A09.05.090 Исследование уровня хорионического гонадотропина (свободная бета-субъединица) в сыворотке крови
- A12.20.001 Микроскопическое исследование влагалищных мазков
- A27.05.062 Молекулярно-генетическое исследование мутаций в гене EGFR в крови методом ПЦР
- A12.06.082 Определение антител к Treponema pallidum
- A26.06.038 Определение антител к e-антигену (anti-HBe) вируса гепатита B (Hepatitis B virus) в крови
- A26.06.082.002 Определение антител к бледной трепонеме (Treponema pallidum) иммуноферментным методом (ИФА) в крови
- A26.06.012 Определение антител к бруцеллам (Brucella spp.) в крови
- A26.06.019 Определение антител к вирусу Коксаки (Coxsacki virus) в крови
- A26.06.060 Определение антител к вирусу Крымской-Конго геморрагической лихорадки (Crimean-Congo hemorrhagic fever virus) в крови
- A26.06.084 Определение антител к вирусу ветряной оспы и опоясывающего лишая (Varicella-Zoster virus) в крови
- A26.06.034 Определение антител к вирусу гепатита A (Hepatitis A virus) в крови
- A26.06.041 Определение антител к вирусу гепатита C (Hepatitis C virus) в крови
- A26.06.043 Определение антител к вирусу гепатита D (Hepatitis D virus) в крови
- A26.06.044 Определение антител к вирусу гепатита E (Hepatitis E virus) в крови
- A26.06.047 Определение антител к вирусу герпеса человека 6 типа (Herpesvirus 6) в крови
- A26.06.088 Определение антител к вирусу клещевого энцефалита в крови
- A26.06.056 Определение антител к вирусу кори в крови
- A26.06.071 Определение антител к вирусу краснухи (Rubella virus) в крови
- A26.06.062 Определение антител к возбудителю описторхоза (Opisthorchis felineus) в крови
- A26.06.011 Определение антител к возбудителям иксодовых клещевых боррелиозов группы Borrelia burgdorferi sensu lato в крови
- A26.06.006 Определение антител к грибам рода аспергиллы (Aspergillus spp.) в крови
- A26.06.029 Определение антител к капсидному антигену (VCA) вируса Эпштейна-Барр (Epstein - Barr virus) в крови
- A26.06.051 Определение антител к легионелле пневмонии (Legionella pneumophila) в крови
- A26.06.053 Определение антител к лейшмании (Leischmania) в крови
- A26.06.054 Определение антител к лептоспире интерроганс (Leptospira interrogans) в крови
- A26.06.063 Определение антител к парвовирусу B19 (Parvovirus B19) в крови
- A26.06.040 Определение антител к поверхностному антигену (HBsAg) вируса гепатита B (Hepatitis B virus) в крови
- A26.06.067 Определение антител к респираторному синцитиальному вирусу (Respiratory syncytial virus) в крови
- A26.06.068 Определение антител к риккетсиям - возбудителям клещевых пятнистых лихорадок (Rickettsia spp.) в крови
- A26.06.073 Определение антител к сальмонелле кишечной (Salmonella enterica) в крови
- A26.06.074 Определение антител к сальмонелле паратифа A (Salmonella paratyphy A) в крови
- A26.06.075 Определение антител к сальмонелле паратифа B (Salmonella paratyphy B) в крови
- A26.06.076 Определение антител к сальмонелле паратифа C (Salmonella paratyphy C) в крови
- A26.06.077 Определение антител к сальмонелле тифи (Salmonella typhi) в крови
- A26.06.086 Определение антител к сероварам иерсинии энтероколитика (Yersinia enterocolitica) в крови
- A26.06.078 Определение антител к стафилококкам (Staphylococcus spp.) в крови
- A26.06.080 Определение антител к токсокаре собак (Toxocara canis) в крови
- A26.06.081 Определение антител к токсоплазме (Toxoplasma gondii) в крови
- A26.06.079 Определение антител к трихинеллам (Trichinella spp.) в крови
- A26.06.090 Определение антител к хантавирусам, возбудителям геморрагической лихорадки с почечным синдромом в крови
- A26.06.025 Определение антител к эхинококку многокамерному (Echinococcus multilocularis) в крови
- A26.06.026 Определение антител классов A, M, G (IgA, IgM, IgG) к амебе гистолитика (Entamoeba histolytica) в крови
- A26.06.017 Определение антител классов A, M, G (IgA, IgM, IgG) к хламидии птичьей (Chlamydia psitaci) в крови
- A26.06.032 Определение антител классов A, M, G (IgM, IgA, IgG) к лямблиям в крови
- A26.06.005 Определение антител классов M, G (IgM, IgG) к аденовирусу (Adenovirus) в крови
- A26.06.028 Определение антител классов M, G (IgM, IgG) к вирусу Эпштейна-Барра (Epstein - Barr virus) в крови
- A26.06.048 Определение антител классов M, G (IgM, IgG) к вирусу иммунодефицита человека ВИЧ-1 (Human immunodeficiency virus HIV 1) в крови
- A26.06.049 Определение антител классов M, G (IgM, IgG) к вирусу иммунодефицита человека ВИЧ-2 (Human immunodeficiency virus HIV 2) в крови
- A26.06.094 Определение антител классов M, G (IgM, IgG) к иерсинии псевдотуберкулеза (Yersinia pseudotuberculosis) в крови
- A26.06.093 Определение антител классов M, G (IgM, IgG) к иерсинии энтероколитика (Yersinia enterocolitica) в крови
- A26.06.057 Определение антител классов M, G (IgM, IgG) к микоплазме пневмонии (Mycoplasma pneumoniae) в крови
- A26.06.095 Определение антител классов M, G (IgM, IgG) к шигелле Боуди (Shigella boydii) в крови
- A26.06.097 Определение антител классов M, G (IgM, IgG) к шигелле Зонне (Shigella sonnei) в крови
- A26.06.098 Определение антител классов M, G (IgM, IgG) к шигелле Флекснера (Shigella flexneri) в крови
- A26.06.096 Определение антител классов M, G (IgM, IgG) к шигелле дизентерии (Shigella dysenteriae) в крови
- A26.30.004.018 Определение карбапенемаз иммуноферментным методом
- A09.20.012 Определение содержания антиспермальных антител в цервикальной слизи (посткоитальный тест)
- B01.070.012 Патронаж выездной патронажной бригадой отделения выездной патронажной паллиативной медицинской помощи детям
- A10.20.001.003 Преимплантационное генетическое исследование на структурные хромосомные перестройки (ПГТ-СП)